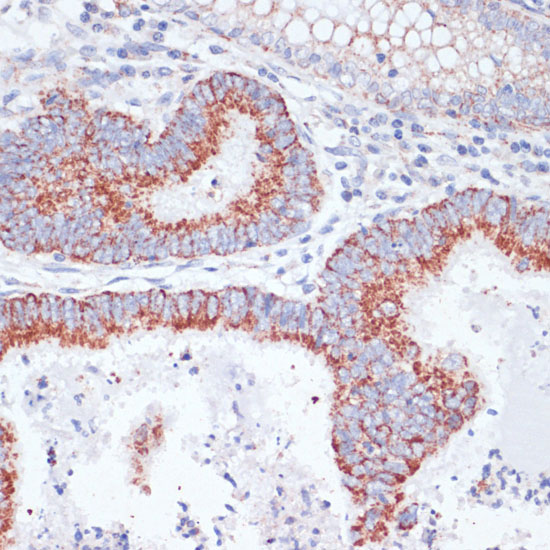

Product NameTFRC Antibody
Host SpeciesRabbit
ClonalityPolyclonal
PurificationAntibodies were purified by affinity purification using immunogen.
ApplicationsWB IHC IF
Species ReactivityHu Ms Rt
SpecificityThe antibody detects endogenous level of total TFRC protein.
Immunogen TypeRecombinant Protein
Immunogen DescRecombinant protein of human TFRC.
Target NameTFRC
ConjugateUnconjugated
Other NamesT9; TR; TFR; p90; CD71
Accession NoSwiss-Prot:P02786
NCBI Gene ID:7037
Uniprot
P02786
Gene ID
7037;
Sdspage MW84KD
Concentration1.0mg/ml
FormulationSupplied at 1.0mg/mL in phosphate buffered saline (without Mg2+ and Ca2+), pH 7.4, 150mM NaCl, 0.02% sodium azide and 50% glycerol.
StorageStore at -20˚C

Yes
Yes



